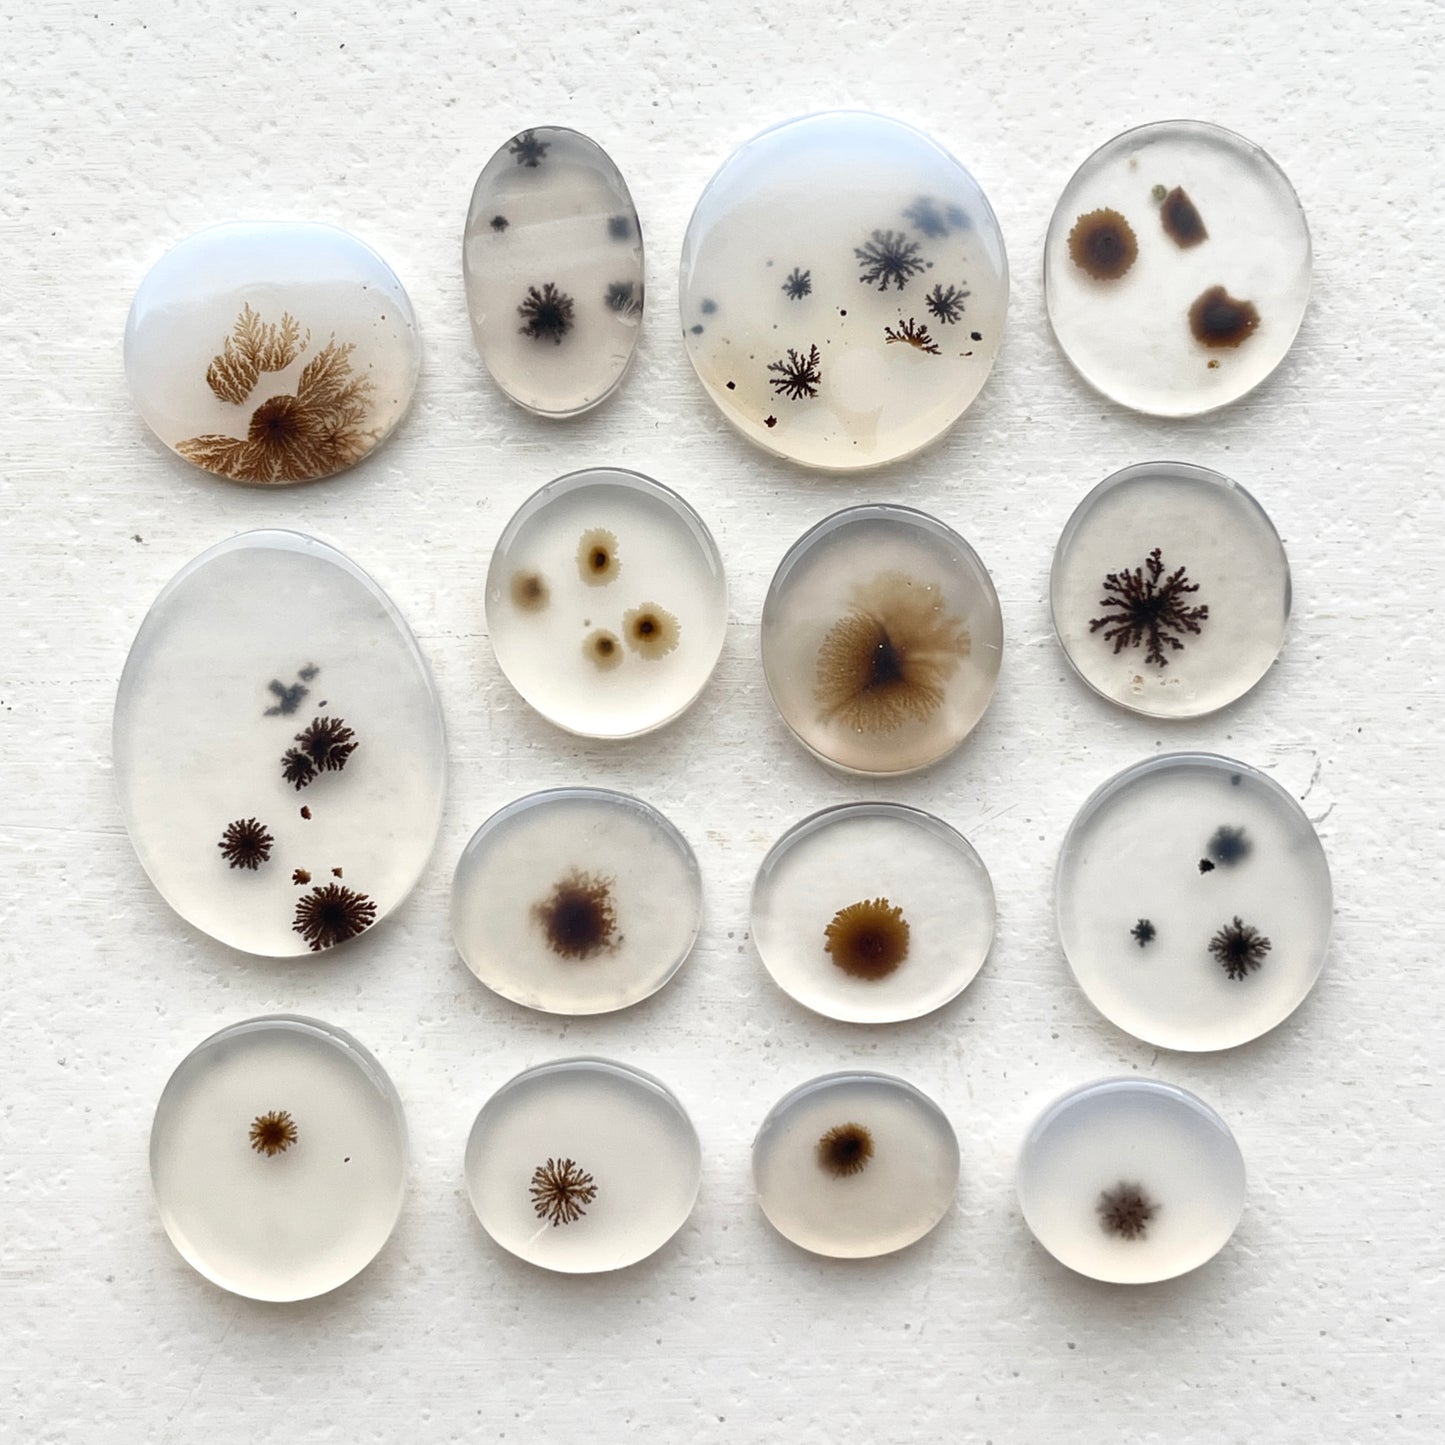
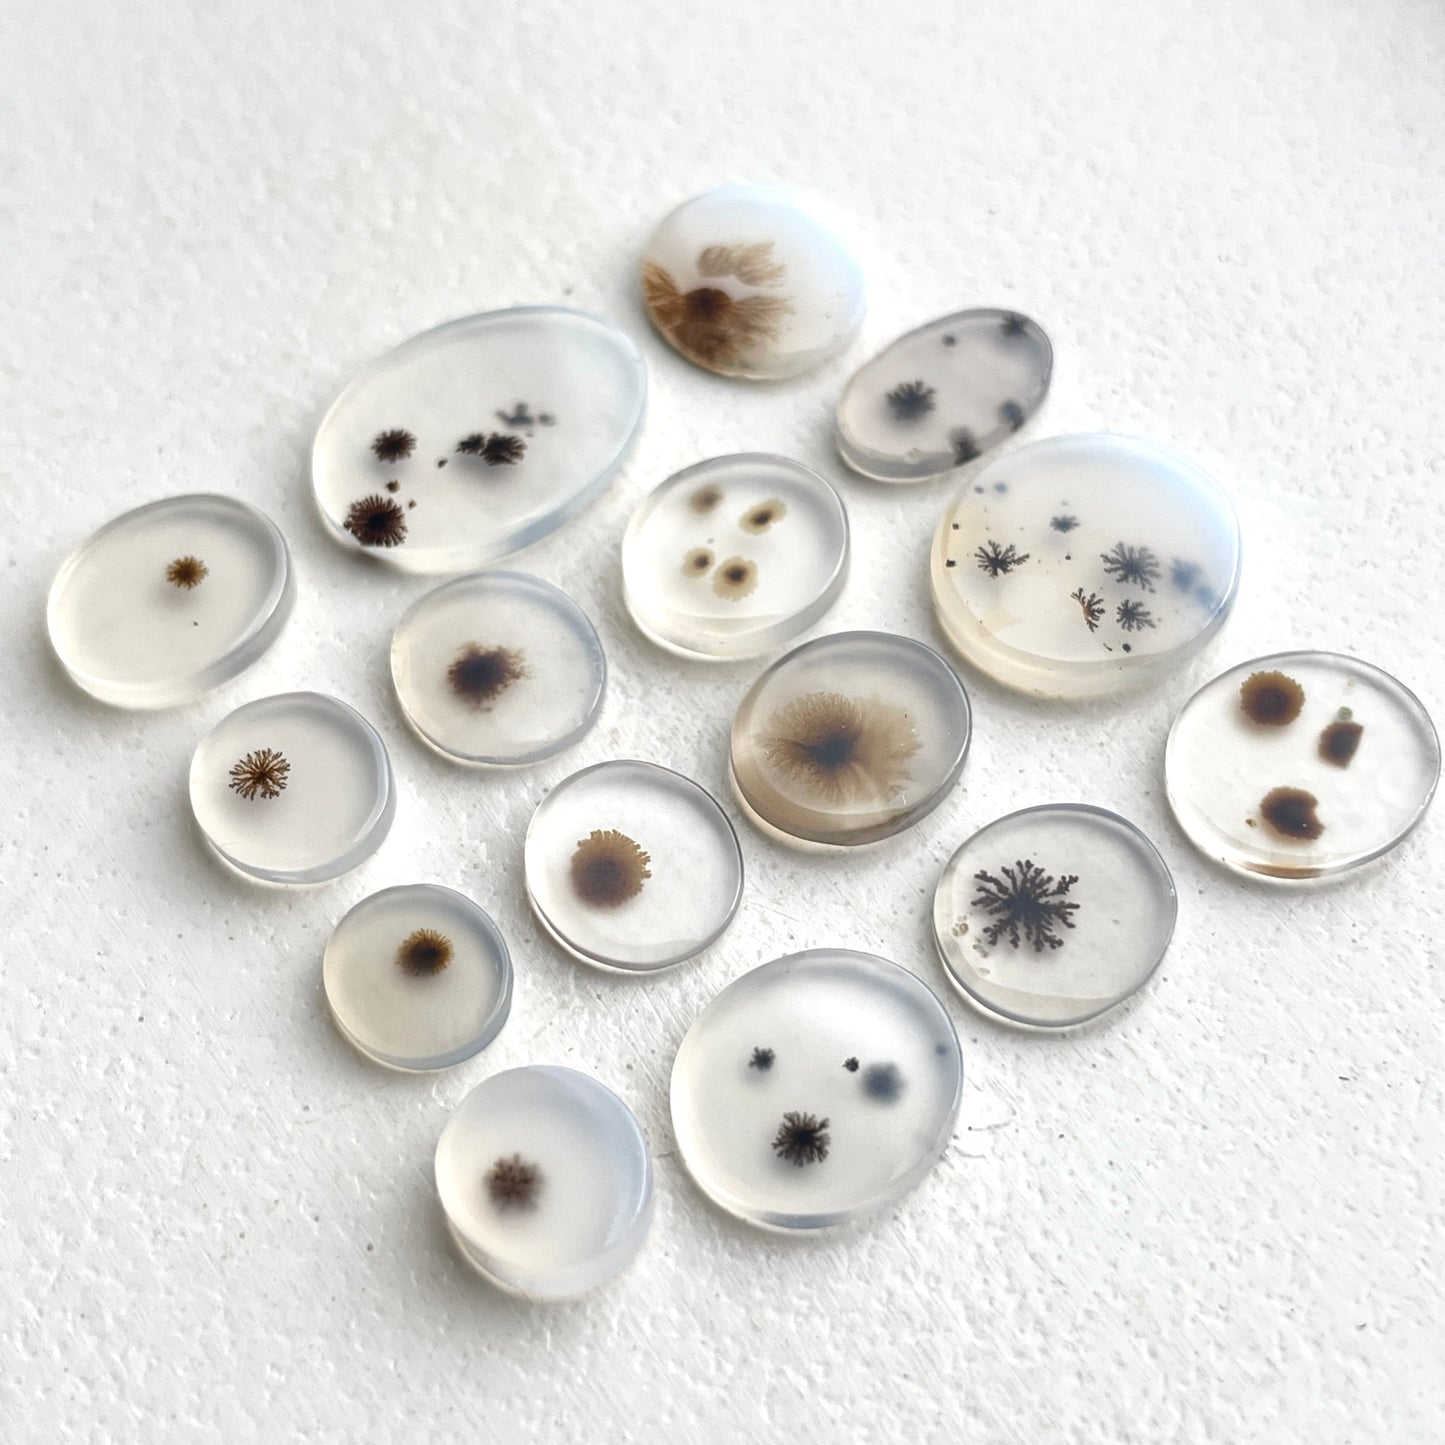
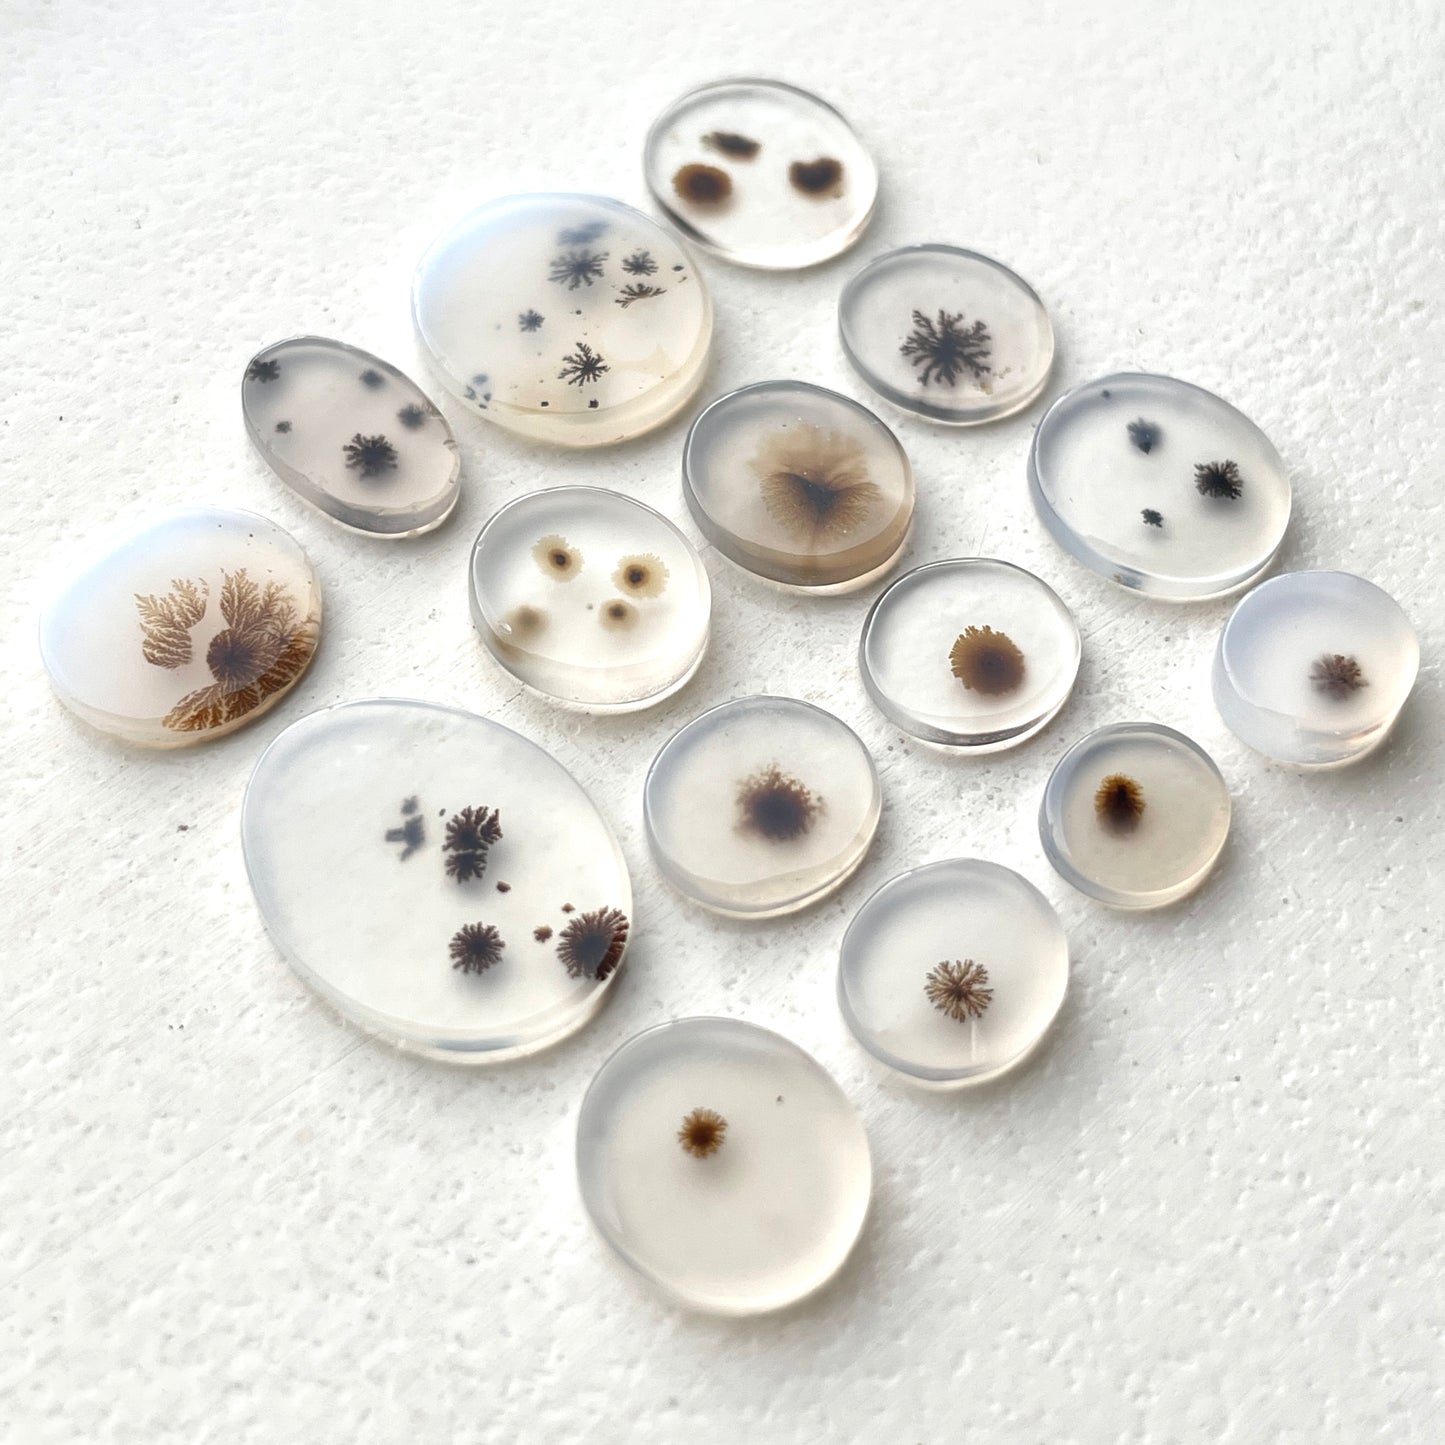

Scenic Dendritic Agate Cabochon Smooth - Choose your Stone (D)
Scenic Dendritic Agate Cabochon Smooth - Choose your Stone (D)
This listing is for 1x Scenic Dendritic Agate Cabochon as shown. Select your stone from the menu below.
Size : Height ranges from , flat back
Country of Origin : India
For size reference, the 20c Australian coin in the photo measures 28.6mm
100% natural (no treatment, no dye)
Important to Note
Important to Note
PLEASE NOTE: Due to the nature of natural, untreated gemstones, no 2 stones are ever identical to one another. You may also notice coloured or black “specks” or what may be noticed as “cracks” in your gemstone. These are not considered defects or faults, but rather, naturally occurring inclusions and is what makes each gemstone unique in itself. :-)
About our Gemstones
About our Gemstones
Natural Beauty
Unless otherwise specified, C+G gemstones are natural creations of Mother Earth, untouched by dyes or fillers. Each gemstone is unique, with natural inclusions, internal colour variations, and small "imperfections" that add to their character and allure.
Superior Quality
We meticulously hand-select the finest gemstones for every set we offer. Each stone is precision-cut to enhance the inherent beauty of the high-quality natural rough materials from which they are crafted.
Effortless Setting
Most of our gemstones feature thick, high domes ranging from 3 to 6mm—2-3 times thicker than the market-average smooth/rose cut cabochons. This design makes them easier to set and gives jewellery a more elegant, valuable, and substantial appearance. The thickness allows light to illuminate the stone from the sides, enhancing its brilliance, whether set in a bezel or a handmade prong setting.
Vibrant Colour
Handpicked for their intense colour saturation and unique colour variations, our gemstones are photographed in 100% natural lighting to capture their true beauty. While we strive to represent the gemstones' colours accurately, please note that different screens and brightness settings can affect how the colours appear.
Ethical Sourcing
We establish positive, open, and collaborative relationships with our suppliers, sourcing exclusively from mines adhering to ethical safety standards and fair wages. Our stones are cut in a 'fair trade' manner, allowing lapidary cutters to set their rates and work in their own facilities (often their own homes).
Shipping & Returns
Shipping & Returns
We ship worldwide (to most countries). All items are shipped from our office in Melbourne, Australia.
To view our full shipping rates, click here
We offer refunds, replacements, or credit notes for damaged or incorrect products if reported within 24 hours. Change of mind returns are generally not accepted but may be considered with a 20% restocking fee. Refunds take 3-5 business days.
To view our full returns/refunds policy, click here
Rewards & Discounts
Rewards & Discounts
Share